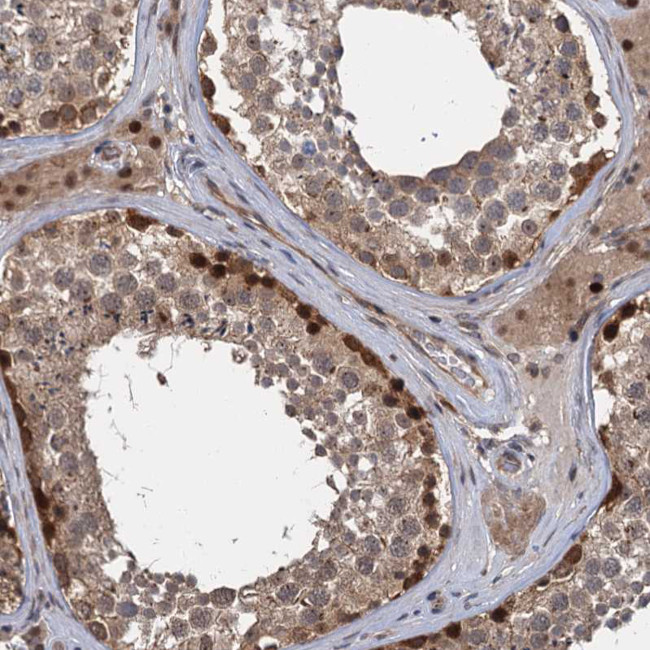
C12orf41 Antibody in Immunohistochemistry (Paraffin) (IHC (P))

Search
Invitrogen
C12orf41 Polyclonal Antibody
{{$productOrderCtrl.translations['antibody.pdp.commerceCard.promotion.promotions']}}
{{$productOrderCtrl.translations['antibody.pdp.commerceCard.promotion.viewpromo']}}
{{$productOrderCtrl.translations['antibody.pdp.commerceCard.promotion.promocode']}}: {{promo.promoCode}} {{promo.promoTitle}} {{promo.promoDescription}}. {{$productOrderCtrl.translations['antibody.pdp.commerceCard.promotion.learnmore']}}




Please note: We are reviewing Western blot images included in the antibody testing data in our catalog, including those provided by third parties. Unless expressly labeled or annotated as “raw-unedited”, Western blot images included in the antibody testing data in our catalog may have been edited, optimized or otherwise adjusted for presentation.
产品信息
PA5-58415
种属反应
宿主/亚型
分类
类型
抗原
偶联物
形式
浓度
规格
纯化类型
保存液
内含物
保存条件
运输条件
RRID
产品详细信息
Immunogen sequence: MKKTNPGPVG ETLLCQLSSY AKTELGSQTP ESSRSEASRI LDEDSWSDGE QEPITVDQTW RGDPDSEADS IDSDQEDP
Highest antigen sequence identity to the following orthologs: Mouse - 96%, Rat - 96%.
靶标信息
The C12orf41 gene, also known as CFAP70 (Cilia and Flagella Associated Protein 70), is located on chromosome 12 and encodes a protein that is essential for the proper function of cilia and flagella. The CFAP70 protein plays a critical role in the assembly and maintenance of axonemal structures, which are core components of cilia and flagella. Cilia and flagella are vital for various cellular processes, including motility, fluid movement across cell surfaces, and signal transduction. Mutations in CFAP70 have been linked to primary ciliary dyskinesia (PCD), a genetic disorder characterized by chronic respiratory tract infections, abnormal situs (organ positioning), and infertility due to defective motility of cilia and flagella. CFAP70 is also involved in the regulation of dynein arms and radial spokes, which are necessary for the effective beating of cilia and flagella. Research into CFAP70 continues to uncover its multifaceted roles in cellular function and its potential implications in ciliopathies.
仅用于科研。不用于诊断过程。未经明确授权不得转售。
篇参考文献 (0)
生物信息学
蛋白别名: KAT8 regulatory NSL complex subunit 2; Non-specific lethal 2 homolog; NSL complex protein NSL2
基因别名: C12orf41; KANSL2; NSL2
Entrez Gene ID: (Human) 54934